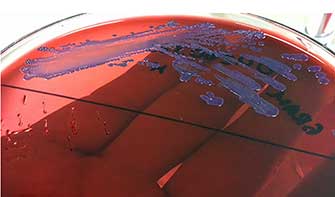

Casos clínicos
Melioidosis: reporte del primer caso en el estado de Sonora, México*
Melioidosis: report of the first case in a northern state of México
Melioidosis: reporte del primer caso en el estado de Sonora, México*
Revista Médica del Instituto Mexicano del Seguro Social, vol. 55, núm. 2, pp. 257-259, 2017
Instituto Mexicano del Seguro Social
Resumen: La melioidosis, infección ocasionada por la bacteria Burkhordelia pseudomallei, comprende síndromes clinicos heterogéneos de evolución aguda o crónica. El objetivo del presente artículo es informar de un caso con presentación poco habitual y fuera del contexto epidemiológico conocido. Presentamos el caso de un hombre de 48 años de edad que acude a nuestro hospital por fiebre e historia de absceso en región subescapular derecha, a la exploración física mostraba hepatomegalia, esplenomegalia y fiebre, sin manifestar síntomas pulmonares. Dentro de su protocolo de estudio se concluyó que padecía múltiples abscesos en hígado y bazo, requiriendo de exploracion quirurgica y antibióticos (meropenem/vancomicina). Mediante hemocultivos hubo desarrollo de Burkhordelia pseudomallei, agregando al manejo trimetropima/sulfametoxazol con resolución de síntomas.
Palabras clave: Melioidosis, Burkhordelia pseudomallei, Absceso.
Abstract: The Melioidosis, is an infection caused by Burkhordelia pseudomallei that comprises heterogeneous clinical syndromes with acute or chronic evolution. The objective of this article is to report a case with unusual presentation and outside the known epidemiological context. We present the case of a 48-year-old man who came to our hospital with fever and a history of an abscess in the right subscapular region, physical examination showed hepatomegaly, splenomegaly, fever, without pulmonary symptoms. Within study it reveal multiple abscesses in liver and spleen, requiring surgical exploration and antibiotics (meropenem/vancomycin). Blood cultures reveal Burkhordelia pseudomallei adding trimethoprim/sulfamethoxazole with resolution of symptoms.
Keywords: Melioidosis, Burkhordelia pseudomallei, Abscess.
Introducción
La enfermedad conocida como melioidosis consiste en síndromes clínicos heterogéneos ocasionados por la bacteria Burkhordelia pseudomallei. Las características clínicas de este tipo de infección resultan en cuadros agudos o crónicos, de baja o poca mortalidad, dependientes del inóculo bacteriano y de la localización de la infección. Se comporta como infección endémica y comunitaria (por ejemplo, infección en piel y neumonía por citar los más frecuentes) en regiones de Australia y Asia, siendo los reportes en el continente americano pocos, y en México, raros.1
En México, ante su baja frecuencia (epidemiologia no conocida), la sospecha clínica es baja, siendo diagnosticada con base en la identificación automatizada en el laboratorio de microbiología. Se presenta un caso con evolución crónica sin relación epidemiologia aparente.
Presentación del caso
Hombre de 48 años que ingresa por sepsis con foco infeccioso en piel. Originario y residente de Hermosillo, México, dedicado al cuidado de su hogar, padece diabetes mellitus tipo 2, negó viajes fuera de su área de residencia. Inicia su padecimiento hace 4 meses con presencia de una lesión en piel catalogada como absceso, localizada en región subescapular derecha, blanda, dolorosa y con aumento de temperatura, de aproximadamente 4 cm de diámetro; la cual, durante estos 4 meses, se manejó con múltiples antibióticos (clindamicina, vancomicina) teniendo una respuesta parcial con recaídas. A su llegada a nuestro hospital se identificó fiebre, de 7 días de evolución, llegando hasta los 40 grados Celsius, constante en todo el dia, sin patrón característico, acompañada de escalofríos, mejorando con medios físicos y antipiréticos; se procedió al drenaje del absceso obteniendo material purulento, sin lograr aislamiento microbiológico; por uso previo de antibióticos y con sospecha en bacterias comunitarias resistentes, aunado al cuadro séptico del enfermo, se instauró tratamiento con meropenem 3gr/día y vancomicina 2 g/día, sin embargo evoluciono tórpidamente hacia la sepsis, por lo que se realizó extensión de protocolo diagnóstico, concluyendo en múltiples abscesos en bazo e hígado optando por procedimiento quirúrgico, realizando esplenectomía y drenaje de absceso en hígado. Su evolución, a los 7 días, con el tratamiento antimicrobiano comentado, resulto tórpida ya que continuaba febril y con leucocitosis, mediante hemocultivo se tuvo aislamiento de bacilos gramnegativos (figura 1), los cuales crecieron, a las 48 horas de incubacion, en agar sangre y MB como colonias redondeadas de bordes mal definidos, rugosas, sin evidenciar fermentación de lactosa (figura 2); mediante método automatizado Vitek (bioMérieux; Durham, NC) se identificó como Burkhordelia pseudomallei. Con base en esto, se modificó terapia antimicrobiana, sumando al meropenem, trimetromima/sulfametoxazol a dosis de 320/1600 mg (IV) cada 12 horas, eliminando la vancomicina.

Con dicha modificación, se presentó resolución de síntomas en las primeras 48 horas de tratamiento. Cursó con estabilidad clínica, optando por 2 semanas de tratamiento endovenoso, con egreso a domicilio a completar tratamiento con fase de erradicación, a base de trimetromima/sulfametoxazol a dosis de 320/1600 mg (VO) cada 12 horas. A la revisión en consulta externa, un mes posterior al egreso, el paciente continuaba estable sin nuevos datos de infección.
Discusión
Los síndromes clínicos característicos de una infección por B. pseudomallei resultan en neumonía e infecciones de piel y tejidos blandos de adquisición comunitaria y con evolución aguda.1,2 El presente caso denota una evolución crónica con manifestaciones sistémicas de carácter intermitente. Lo que llama la atención de esta presentación clínica es la ausencia de datos pulmonares, siendo estos los más frecuentes en pacientes con melioidosis.3 Dentro de nuestro país, los reportes de este tipo de infección van en ascenso (mejora en sistemas de identificacion), sin embargo continúan siendo pocos.3
La Burkhordelia pseudomallei en su micromorfologia resulta en un bacilo gramnegativo, no encapsulado, móvil, que en la tinción de Gram se observa con el centro claro y los extremos oscuros. Las colonias en agar sangre se aprecian secas y de color amarillo oscuro, en agar EMB o McConkey se aprecian colonias purpuras. La bacteria tiene afinidad por órganos del sistema fagocítico mononuclear y puede producir abscesos en piel, tejido blando, articulaciones y huesos.2 Ante las diversas presentaciones clínicas, y como gran parte de las infecciones que afligen al ser humano, la patogenia recae en la inoculación directa, diseminación hemática o por continuidad.
Las opciones terapéuticas resultan limitadas, ya que es un microbio resistente a la mayoría de los betalactámicos (ampicilina, penicilinas, cefalosporinas de primera y segunda generación) y aminoglucósidos (gentamicina, tobramicina y estreptomicina). El tratamiento recomendado es la administración de un betalactámico (ceftazidima 50 mg/kg, máximo 2 g IV cada 6 h; meropenem 25 mg/kg, máximo 1 g IV cada 8 h, o imipenem 25 mg/kg, máximo 1 g IV cada 6 h) intravenoso en la fase aguda, seguida de una fase de erradicación con trimetropin/sulfametoxazol por vía oral durante tres a seis meses, pudiendo utilizarse otros antibióticos como piperacilina/tazobactam, amoxicilina/clavulanato y doxiciclina, que presentan tazas de efectividad adecuada.4
En el caso presentando, la evolución clínica refractaria, al inicio del tratamiento con meropenem, se puede esperar ante presencia de abscesos en abdomen (alto inóculo bacteriano), por otro lado el uso de TMP/SMX resultó en mejoría del cuadro, aunque no se realizó antibiograma, se han documentado casos de B. pseudomallei resistentes a betalactámicos (ceftazidima), pero no a meropenem, aun así, esta bacteria, como la gran mayoría de las bacterias, tiene capacidad de generar resistencia extendida incluso a los carbapenémicos. En vista del territorio geográfico que ocupa el estado de Sonora (desierto) resulta una presentación sin aparente trasfondo epidemiológico de base, siendo comúnmente reportados casos en zonas tropicales. Como un dato especulativo hacia la posible etiología del cuadro actual, el enfermo era jubilado, con amplio interés en jardinería, siendo esta bacteria ubicua de terrenos húmedos.
Como conclusión, se expresa un caso de melioidosis en una zona geográfica no endémica, con presentación clínica poco habitual, pobre respuesta a un tratamiento considerado como primera línea (meropenem) y con una evolución satisfactoria.
Agradecimientos
Al servicio de microbiología por su dedicación y compromiso.
Referencias
1. Truong K. Moghaddam S, Al Saghbini S. Case of lung mass due to Melioidosis in Mexico. Am J Case Rep. 2015;16:272-5.
2. Martínez-Hernández L, González-Híjar A, Valdéz-Vázquez R, García-López S, González-Chon O. Melioidosis: Reporte de caso y revisión de la literatura. Neumol Cir Torax. 2013;72(4):291-298.
3. Lee SH, Nathan S. Burkholderia pseudomallei: an update on disease, virulence and host interaction. Malays Appl Biol. 2013;42(1):1-14.
4. White NJ. Melioidosis. Lancet. 2003;361:1715-1722.
Notas
Notas de autor
dr.boroel@gmail.com
Información adicional
PMID PubMed: https://www.ncbi.nlm.nih.gov/pubmed/28296377
Enlace alternativo
http://revistamedica.imss.gob.mx/editorial/index.php/revista_medica/article/view/1382/1985 (pdf)